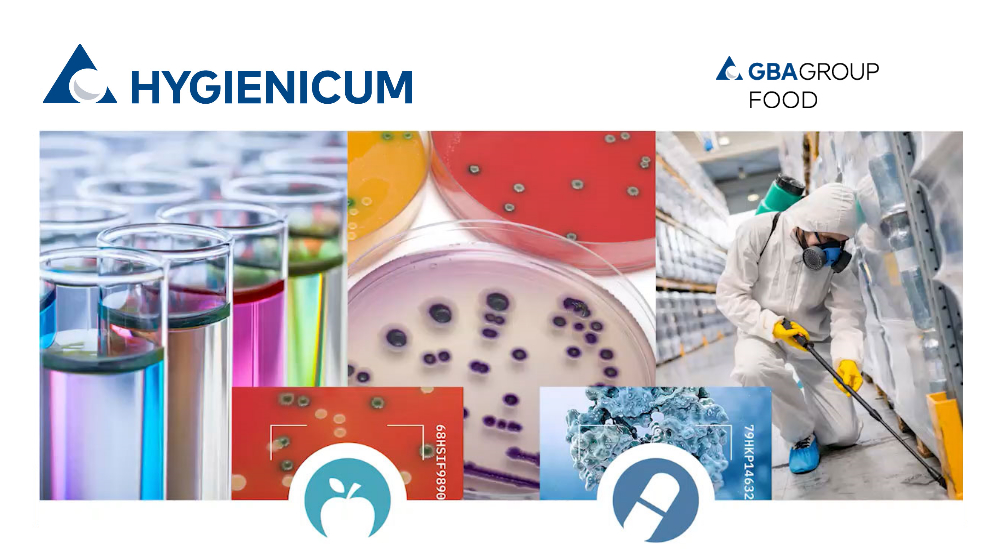
Logo

Zur Verstärkung unseres Teams am Standort Graz suchen wir Dich als
Chemielaborant:in / CTA (m/w/d)
(unbefristet, Vollzeit, 40 Std./Woche)
Wir freuen uns auf Deine Bewerbung (Anschreiben, Lebenslauf, Zeugnisse und die Angabe Deiner Gehaltsvorstellung).
Bitte bewirb Dich ausschließlich über unser Bewerbertool. Bewerbungen per E-Mail oder per Post können leider nicht berücksichtigt werden.
Die GBA Group ist ein internationales Life Science Dienstleistungsunternehmen mit einem breiten Angebot an analytischen, logistischen und fachspezifischen Services in den Bereichen Pharma, Medizinprodukte, Kosmetika, Chemie, Lebensmittel, Trinkwasser und Umwelt. Das Leistungsangebot umfasst Laboranalytik, Datenmanagement, spezielle logistische Dienstleistungen im Bereich klinischer Studien sowie die Beratung von privaten Unternehmen und öffentlichen Einrichtungen im Zusammenhang mit deren Aktivitäten im Bereich Forschung, Produktentwicklung, Markterschließung und Verbraucherschutz.
Als österreichisches Kompetenzzentrum für Lebensmittelsicherheit und Betriebshygiene agiert HYGIENICUM GmbH, Institut für Lebensmittelsicherheit und Hygiene, seit 1998 erfolgreich auf dem europäischen Markt. Mit der Erfahrung auf betrieblicher Ebene und Know-how in den Bereichen Lebensmitteltechnologie, modernster Labordienstleistungen, Consulting und der Vernetzung mit externen Partnern schafft HYGIENICUM eine breite Kompetenz.
Zusammenhalt und Spaß an der Arbeit zeichnen unsere Teamchemie aus. Wir wissen, dass unsere Erfolge in den eingespielten Teams unserer Mitarbeiterinnen und Mitarbeiter wurzeln. Deswegen bieten wir jedem Einzelnen die Chance zu wachsen und fördern Fach- und Führungskräfte. Bei uns entstehen stets neue Aufstiegschancen, Perspektiven und Möglichkeiten. In gegenseitiger Unterstützung wachsen wir weiter.
#teamchemie #wissenschaftmitleidenschaft #gemeinsamwachsen #jointheteam
HYGIENICUM GmbH
Frau Silvia Rath
Robert-Viertl-Straße 7
8055 Graz, Österreich